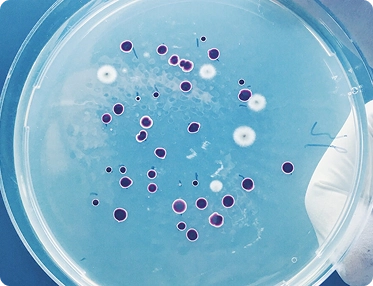
Plastic

First Integrated Hospital For
Eye Diseases In India
Jeena Sikho HiiMS establishes the first integrated hospital for eye diseases that incorporates Ayurveda, Naturopathy, Homeopathy, and Unani therapies together with modern sciences.
What are Eye Diseases?
-
Eye diseases are conditions where different parts of the eye stop working properly, affecting how clearly a person can see and how comfortable the eyes feel in daily life.
-
Normally, the eyes work like a natural camera receiving light, focusing it, and sending clear signals to the brain so we can see without strain.
-
But when the eyes become weak, inflamed, dry, infected, or pressured from inside, that when eye disorders begin because the eyes can't maintain proper clarity, moisture, and healthy vision.
-
This disturbance leads to the common symptoms of eye problems blurry vision, redness, dryness, itching, headaches, watery eyes, difficulty seeing at night, and sometimes pain or heaviness around the eyes.
-
Over time, if not treated properly, eye diseases can point to deeper issues like cataract, glaucoma, diabetic eye damage, retina weakness, or long-standing nerve pressure that need timely and holistic care.
Causes of Eye Diseases

Excess screen time

Nutrient deficiencies

High blood sugar

High eye pressure

Chronic eye dryness

Bacterial or viral infection

Sunlight overexposure

High blood pressure

Hormonal imbalance
People Living With Vision Loss in India
270,000K+
Preventable or Treatable Vision-Loss Cases
85%+
People Suffering From Corneal Blindness in India
1,200K+
Eye Diseases Care at Jeena Sikho HiiMS
The Four Healing Pillars
In Ayurveda, research is built around four pillars - Aahar (Food), Vihar (Lifestyle), Shaman (Medicines), and Shodhan (Therapies) - each working together to restore balance, strengthen immunity, and awaken the body's natural healing ability.
Naturopathy
Zero-Volt Therapy
-
What Is This Therapy
An innovative healing technique that helps the body regain its natural electrical balance through a special zero-volt bedsheet designed to ground and stabilise the body bioelectrical field.
-
How It Works
It helps restore smooth bioelectric flow, reduces internal strain, and supports relaxation of muscles and tissues at a cellular level.
-
Why This Therapy
When the bodys electrical signals become disturbed, it may lead to inflammation, stiffness, or toxin accumulation in different areas. Zero-Volt Therapy helps neutralise excess charge, promoting better balance, calmness, and natural detoxification.
-
Benefits
May help ease muscular fatigue, reduce cellular stress, support toxin clearance, and improve overall energy flow and coordination within the body.
Hot Water Immersion
-
What Is This Therapy
Hot Water Therapy involves immersing the body in warm water to support natural relaxation and overall healing responses.
-
How It Works
The warmth encourages better blood circulation, helping oxygen and nutrients reach muscles and tissues more efficiently.
-
Why This Therapy
Heat helps loosen tight muscles, open pores, and support toxin release through gentle sweating, which reduces overall strain in the body.
-
Benefits
Promotes detoxification, eases muscular fatigue, calms the nervous system, and leaves the body feeling lighter, relaxed, and refreshed.
Akshi Tarpan
-
What Is This Therapy
Akshi Tarpan is a classical Ayurvedic eye-nourishing therapy where medicated oil or ghee is gently held over the eyes.
-
How It Works
It deeply lubricates, cools, and nourishes the eye tissues, helping soothe strain, dryness, and irritation.
-
Why This Therapy
The therapy strengthens ocular muscles, calms inflammation, and supports better tear formation.
-
Benefits
Clearer vision, reduced eye fatigue, improved moisture, and enhanced overall eye strength.
Panchakarma Therapies
The five Ayurvedic cleansing methods that deeply purify the body and help repair and rejuvenate the whole body:
Vamana
-
What Is This Therapy
Vamana is a therapeutic process from Panchakarma that helps remove toxins from the internal upper body.
-
How It Works
The process involves herbal preparations that gently induce vomiting to cleanse the digestive tract.
-
Why This Therapy
It removes excess mucus and toxins accumulated in the stomach and chest, improving digestion and respiration.
-
Benefits
Respiratory Relief, Digestive Improvement, Better Skin Health, Improved Mental Clarity, and Strong Immunity.
Virechana
-
What Is This Therapy
Virechana is a detoxification therapy focused on purifying the liver and intestines through controlled motions.
-
How It Works
Gentle herbal formulations are used to stimulate natural bowel movements and clear internal waste.
-
Why This Therapy
It helps eliminate deep-seated toxins, balancing the bodys Pitta and supporting overall metabolic health.
-
Benefits
You experience better digestion, enhanced energy, and a sense of lightness and clarity in the body.
Basti
-
What Is This Therapy
Basti is an Ayurvedic therapy that uses herbal oil or decoction enemas to cleanse and nourish the colon.
-
How It Works
Medicinal oils are gently introduced into the colon to remove toxins and lubricate internal tissues.
-
Why This Therapy
Two main basti therapies include Niruha Basti (Asthapana Basti) and Anuvasana Basti to clean the colon, which is the root of many imbalances; cleansing it supports gut health, immunity, and mental clarity..
-
Benefits
Improved digestion, reduced inflammation, balanced Vata energy, and overall body rejuvenation.
Nasya
-
What Is This Therapy
Nasya is a traditional Ayurvedic therapy involving the pouring of herbal oils through the nose.
-
How It Works
Medicinal oils help remove toxins, mucus, and blockages from the nasal passages and sinuses.
-
Why This Therapy
The nose is considered the gateway to the head, and cleansing it supports mental clarity and respiratory health.
-
Benefits
Clear breathing, reduced stress, sharper focus, and enhanced brain function.
Raktmokshana
-
What Is This Therapy
Raktmokshana is a traditional Ayurvedic blood purification therapy that removes impure blood from the body.
-
How It Works
The therapy removes toxins through controlled methods like leech therapy or venesection.
-
Why This Therapy
It cleans the impurities in the blood, which can lead to skin disorders, inflammation, and other diseases.
-
Benefits
Clearer skin, improved circulation, and enhanced overall vitality.
Start Your Panchakarma Journey
Success Stories

Eye disease

Eye disease
2. Aahar - Eye Diseases Healing Through Food
In Ayurveda, food itself is seen as medicine. An eye-supportive diet helps nourish the optic nerves, reduce inflammation, and strengthen overall vision health, allowing the eyes to repair and function more comfortably.
pH-Balanced Diet
-
What Is pH-Balanced Diet
The pH-Balanced Diet focuses on fresh, raw plant-based foods that naturally nourish and cool the eyes.
-
How It Works
Raw foods help reduce internal heat and inflammation, supporting smoother circulation to the eyes and healthier vision.
-
Why This Diet
Avoiding heavy, oily, and processed foods reduces toxin load, giving the eyes a chance to rest, repair, and function better.
-
Benefits
Better digestion, improved energy, reduced eye strain, and enhanced overall eye strength and clarity.
Autophagy
-
What Is Autophagy
Autophagy is the bodys natural self-cleaning process where old, weak, or damaged cells are broken down and replaced with fresher, healthier ones.
-
How It Works
It helps remove cellular waste, reduces internal inflammation, and supports smoother functioning of tissues and organs by renewing cells from within.
-
Why Autophagy
Fasting naturally activates this repair cycle, allowing the body to clear stressed or worn-out cells and regenerate new ones more efficiently.
-
Benefits
Supports better cellular recovery, reduces toxin load, promotes healthier tissue function, and enhances long-term protection at the cellular level.
Intermittent Fasting
-
What Is This About
Intermittent fasting is a mindful eating pattern that includes planned hours of eating and fasting to support natural healing and metabolic balance.
-
How It Works
Fasting periods give the body a break from continuous digestion, allowing it to reduce oxidative stress, stabilise metabolism, and lower internal inflammation.
-
Why This Fasting
During fasting hours, the body shifts its energy toward repair work restoring cells, clearing toxins, and supporting overall tissue recovery.
-
Benefits
Improved cellular repair, reduced inflammation, better metabolic rhythm, and long-term support for overall body wellness and vitality.
Alkaline Water
-
What Is Alkaline Water
Alkaline water has a higher pH level than regular water, helping maintain internal balance and reducing strain on the eyes.
-
How It Works
It neutralizes excess acidity in the body, lowers oxidative stress, and eases inflammation that can affect eye health.
-
Why drink Alkaline Water
Its mineral-rich nature improves hydration, supports tear production, and helps in cellular repair around the eyes.
-
Benefits
Promotes detoxification, reduces dryness, supports clearer vision, and enhances overall eye vitality.
3. Vihar Lifestyle as Medicine
Vihar focuses on the habits, routines, and environment that shape overall health. These practices help calm the mind, strengthen the spirit, and keep the body in balance.
Mind-Body Healing
-
What Is Mind-Body Healing
A holistic approach that combines natural herbs to balance body and mind.
-
How It Works
It eliminates emotional stress, which often affects physical health and slows healing.
-
Why Mind-Body Healing
The herbs calm the nervous system, uplift mood, and enhance inner stability.
-
Benefits
A peaceful mind, balanced emotions, and a naturally rejuvenated body.
Meditation
-
What Is Meditation
Meditation is the practice of calming the mind through focused awareness and deep breathing.
-
How It Works
It reduces stress hormones and promotes emotional stability.
-
Why Meditate
By focusing inward, it activates the bodys relaxation response and balances the nervous system.
-
Benefits
Improved mental peace, emotional healing, and inner clarity.
Yoga
-
What Is Yoga
Yoga is an ancient mind-body practice combining movement, breath, and mindfulness.
-
How It Works
It strengthens muscles, boosts immunity, and promotes balance in body and mind.
-
Why do Yoga
Through asanas, controlled breathing, and meditation, it enhances circulation and organ function.
-
Benefits
Improved flexibility, stronger immunity, and lasting inner harmony.
Earthing (Grounding)
-
What Is Earthing
Earthing involves direct contact with the earth’s surface through bare feet Walking on green grass or sand.
-
How It Works
The Earth helps absorb the negative energies of the body, making it stress-free and focused immediately.
-
Why This Therapy
Regular grounding helps calm inflammation, balance the nervous system, and stabilize body rhythms, which indirectly supports relaxed eye muscles and smoother visual functioning.
-
Benefits
May improve sleep, ease stress, reduce strain around the eyes, and create a deeper sense of calm and inner balance.
Sunlight as Medicine
-
What Is Sunlight Therapy
Sunlight therapy uses natural sunlight as a healing source for overall wellness.
-
How It Works
Exposure to sunlight boosts Vitamin D, essential for bone, skin, and immune health.
-
Why This Therapy
Sun rays trigger natural Vitamin D synthesis and regulate mood-enhancing hormones.
-
Benefits
Stronger immunity, balanced mood, and improved vitality.
4. Shaman - Healing and Rejuvenation
Shaman focuses on restoring balance through Ayurvedic herbs and natural remedies that work gently yet powerfully on the root cause of disease.
Herbal Formulations
-
What are Herbal Formulations
Gentle blends of pure herbal extracts prepared to support natural eye health.
-
How It Works
They help reduce inflammation, improve circulation around the eyes, and clear internal toxins.
-
Why Herbal Formulations
These herbs nourish eye tissues, protect vision, and support long-term ocular strength.
-
Benefits
Clearer eyes, reduced strain, better comfort, and stronger overall eye wellness.
Ayurvedic Herbs
-
What are These Herbs
A blend of Ayurvedic herbs like Triphala, Haritaki, Amla, Yashtimadhu, Punarnava, and Giloy that naturally support eye strength and clarity.
-
How It Works
These herbs reduce eye inflammation, improve circulation, and nourish the optic nerves for better vision support.
-
Why These Herbs
They help detoxify the eye channels, soothe dryness, and repair stressed eye tissues.
-
Benefits
Sharper vision support, reduced strain, better hydration, and stronger long-term eye health.
53k+ Eye Diseases patients have reversed their Eye
Diseases diseases till now
Ask your questions directly to Acharya Manish Ji
The founder and Chairman of Jeena Sikho HiiMS
Register Now
How to start your healing journey
About Acharya Manish ji
- Acharya Manish ji, a renowned Ayurvedic Guru and a wellness advisor firmly believes in nature healing power.
- As a child, Acharya ji suffered from poor health. Despite several medications, his health did not improve, which made him think beyond conventional treatment.
- He shifted to Ayurvedic therapies that drastically improved his health. This made him start his Ayurvedic journey in 1998, and he made sure to make Ayurveda the first line of treatment.
- He envisioned making this world free from diseases and drugs. As an Ayurvedic Guru, he deeply researched natural herbs and Ayurvedic principles of reversing diseases.
- The positive outcome laid the foundation of Jeena Sikho HiiMS.
- Jeena Sikho HiiMS resulted in the best Ayurvedic therapies to reverse several diseases, making this world a better place to live.
Meet Acharya Manish Ji
A Life Dedicated to Healing
Acharya Manish Ji Recognised for His Ayurvedic Vision

Awarded by Punjab Governor Shri Gulabchand Katariya

Awarded by India Minister of Law and Justice, Shri. Arjun Ram Meghpal

Awarded by Delhi Chief Minister, Shrimati. Rekha Gupta.

Awarded with the Light
Icon Award

Awarded the Imperial Glitz Global Fame Award 2022.

Awarded by the health minister of Punjab, Shri. Chetan Singh Jauramajra.
Ayurvedic Herbs for Eye Diseases
FAQ
If you have constant blurry vision, redness that doesn't go away, pain, headaches, or trouble seeing at night, it better to get your eyes checked. These signs shouldn't be ignored.
Yes. Many eye issues improve when inflammation reduces, toxins clear, and the body gets the right food, rest, and herbal support. People often notice less strain and clearer vision in a few weeks.
Not always. Glasses help temporarily, but if the root cause like dryness, pressure, or weak eye muscles is treated, vision comfort can improve naturally.
Some are, but many drops especially steroids or pressure drops can cause dryness, dependency, or higher eye pressure over time. Always follow under an expert guidance.
This often happens due to screen exposure, dryness, weak eye nerves, or poor blood flow around the eyes. It doesn't always mean a serious disease, but it does need care.
Yes. Both conditions can slowly weaken eye nerves and blood vessels. Regular check-ups and lifestyle improvements are important for protection.